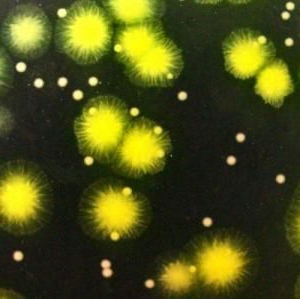

«Colonie» traduit littéralement «règlement» de la langue latine, et toutes les significations de ce mot en termes généraux sont en réalité des règlements. Cependant, la plage de distribution de ces valeurs est assez large. Sans connaître le contexte d'utilisation d'un mot donné dans un discours ou un texte, vous ne saurez jamais ce qu'est une colonie et dans quelle signification le mot est utilisé. Pour les biologistes, il existe une forme sémantique, pour les prisonniers - une autre, pour la population de l'Amérique du Nord et du Sud, de l'Afrique et de l'Asie - la troisième. Avec le passage du temps et la complexité de la construction de la société humaine, la nécessité d'utiliser ce mot avec un sens plus étroit a conduit à l'ambiguïté du terme "colonie". Des époques entières de la vie des personnes et du monde entier sont définies par ce mot.
Biologie. Protozoaires et insectes
Même si nous considérons le terme "colonie" d'un point de vue biologique, il est impossible de voir sans ambiguïté. En termes généraux, une colonie est une combinaison d'individus d'une même espèce vivant ensemble, qui est déterminée par la nécessité de se protéger contre les prédateurs, la reproduction ou l'extraction conjointe d'aliments. C'est ce qu'est une colonie en biologie.
Cependant, une colonie de micro-organismes présente des différences significatives par rapport aux colonies d'oiseaux ou de mammifères. Les micro-organismes sont caractérisés par l'absence de la valeur individuelle d'un organisme particulier. Un principe similaire de construction d'une colonie est également caractéristique des insectes, mais à ce niveau, une séparation fonctionnelle des individus et leur signification pour la colonie apparaissent.
Récemment également, des biologistes ont constaté chez des insectes coloniaux la présence de ce qu'on appelle "l'essaim d'intelligence" - la possibilité de reconstruire la colonie pour une mise en œuvre la plus rationnelle des tâches. Une telle construction permet à certaines espèces de survivre, ne modifiant que l'organisation de la colonie en fonction de conditions de vie spécifiques. Les insectes sont incapables de se reproduire chez la plupart des individus et attribuent ces fonctions aux reines ou aux reines.
Oiseaux
Des organismes plus complexes, tels que les oiseaux, construisent leurs colonies en raison de la nécessité de protéger leurs articulations contre les dangers pendant les migrations, les saisons de reproduction, l'alimentation et les poussins sur l'aile. C'est ce qu'est une colonie d'oiseaux.
Le niveau d'organisation de ces colonies diffère considérablement de celui des organismes inférieurs. Les troupeaux sont dominés par les instincts maternels et sexuels, ce qui entraîne des conflits entre individus, conduisant souvent à la mort d'individus. L'existence même de la meute disparaît après la procréation et la production alimentaire. Les fonctions au sein du groupe sont uniquement réparties par sexe et les différences entre les individus ne sont pas significatives.
Mammifères
En ce qui concerne les mammifères, le terme "colonie" n'est pas correct. Le niveau d'organisation ici est déterminé par la position géographique commune sur un territoire, la présence de dirigeants, la lutte pour la domination entre hommes ne sont pas rares. Les troupeaux peuvent fusionner, se désintégrer en périodes d'accouplement et subir des changements.
Colonisation des terres
Il est impossible d'imaginer une personne qui ignore le sens politique et géographique du mot "colonie". Souvent, la colonisation a apporté l’esclavage et l’oppression aux habitants autochtones, et parfois même le développement, une chance de vie nouvelle et meilleure pour les peuples et des nations entières.
L'ère des grandes découvertes géographiques, qui a débuté au 15ème siècle, a divisé presque le monde entier en colonies et métropoles. La source de ressources pratiquement illimitées est ce qu'est une colonie pour une métropole.Le développement accéléré des métropoles européennes a également eu un revers: en raison de maladies et de l'extermination, des milliers d'habitants des terres colonisées ont péri, des civilisations parfois anciennes, telles que l'empire maya ou la civilisation aztèque, se sont éteintes.
Premiers colonisateurs
L’Espagne, Potugalia et la Hollande figuraient parmi les premiers grands propriétaires coloniaux. Les navigateurs de ces pays ont découvert de nouvelles îles et de nouveaux continents, établi des routes maritimes commerciales et combattu les indigènes. Cependant, en raison d'un certain nombre de circonstances, ces États n'étaient pas en mesure de prendre les devants au début de la course coloniale. L’ouverture des colonies ne donne pas une impulsion au développement de la métropole, mais est perçue comme un terrain propice au profit et à l’enrichissement des guildes commerciales. Avec beaucoup d'autres raisons, cela est devenu la base de la perte de pouvoir des premiers états coloniaux. De nouveaux acteurs puissants sont apparus sur cette scène, qui devaient déterminer l'ordre mondial pour les prochains siècles.
L'Angleterre et les pays de la colonie
À la suite d’une longue et épuisante lutte avec ses concurrents, l’Angleterre est devenue la plus grande puissance coloniale au XVIIIe siècle. Les colonies anglaises sont réparties presque partout dans le monde. Le commerce maritime actif avec le soutien de la marine la plus puissante du monde assurait la domination mondiale de l'Angleterre. Grâce aux ressources gigantesques de la colonie, la révolution industrielle s'est engagée dans la métropole. Dans le premier tiers du XVIIIe siècle, la Grande-Bretagne représentait environ les deux tiers de la production industrielle mondiale. La carte du monde des colonies montre qu'à différentes époques les colonies anglaises occupaient environ la moitié du territoire connu du globe.
Cependant, l’attitude des consommateurs à l’égard des ressources des colonies, de leur population, d’une politique fiscale injuste et souvent prédatrice a conduit à ce que des mouvements de libération aient commencé dans les colonies. En 1783, la Grande-Bretagne a perdu treize colonies après la déclaration d'indépendance des États-Unis. Toutefois, le processus de décolonisation a été très long et n'a finalement pris fin qu'en 1997, lors du transfert de Hong Kong à la possession de la République populaire de Chine.
Colonie pénale
Dans le système de justice, le terme «colonie» est inextricablement lié au terme «colonie correctionnelle». Une colonie pénitentiaire est un lieu de détention concentré et isolé de personnes reconnues coupables de divers crimes d’emprisonnement. Dans notre pays, les colonies correctionnelles sont souvent à l’arrière du pays. En outre, les colonies de détention sont des colonies de peuplement, ce qui souligne le sens du terme et signifie que les criminels vivent dans des conditions isolées sous la surveillance du système correctionnel.
Fiction et espace
En outre, le terme "colonie" est fermement enraciné dans la science-fiction. Par analogie avec les colonies des autres continents, les colonies de stars de l’humanité sont appelées dans la fiction des colonies hors de la Terre. Compte tenu du développement des programmes d'exploration spatiale et des projets d'exploration de la Lune et de Mars, il est possible que, dans les décennies à venir, l'humanité sache ce qu'est une colonie dans l'espace.